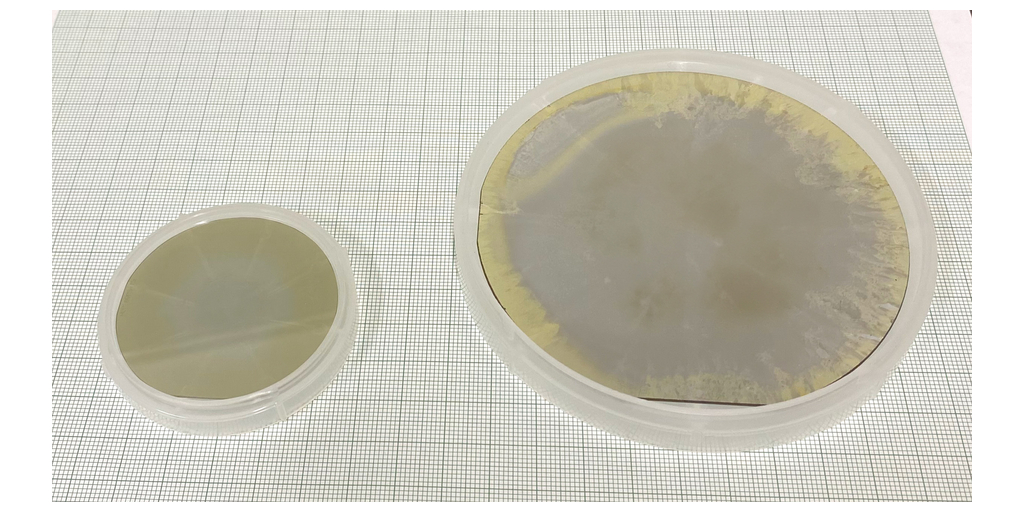

Crystal IS has achieved 4-inch (100 mm) diameter bulk aluminum nitride substrate
GREEN ISLAND, N.Y.–(BUSINESS WIRE)–Crystal IS, an Asahi Kasei company, today announced the successful production of a 4-inch (100 mm) diameter single-crystal aluminum nitride (AlN) substrate. This is the first reported aluminum nitride substrate at this size and demonstrates the scalability of Crystal IS processes for growing AlN bulk single-crystals to meet production demands for this semiconductor material.
Aluminum nitride substrates have low defect densities, high UV transparency, and low concentrations of impurities. AlN is attractive for a variety of industries, such as UVC LEDs and power devices, due to its ultra-wide bandgap and very high thermal conductivity. The 4-inch substrate produced shows a usable area of over 80% based on current requirements for UVC LEDs.
“We are extremely excited to announce the achievement of a 4-inch bulk aluminum nitride substrate,” said Dr. Naohiro Kuze, Executive Fellow at the Research Laboratory of Advanced Science and Technology, Asahi Kasei. “This accomplishment signifies that aluminum nitride is commercially viable for new industries beyond just UVC LEDs.”
Founded in 1997 to develop native aluminum nitride substrates, Crystal IS manufactures UVC LEDs on its commercial process for 2-inch diameter substrates. These LEDs enable industry-leading reliability and performance at the ideal germicidal wavelengths from 260 nm – 270 nm. The current capacity of the facility can meet the volume requirements for consumer devices using UVC LEDs based on the existing 2-inch production line.
“This indicates the scalability of our processes to deliver quality devices on Aluminum Nitride,” said Eoin Connolly, President and CEO of Crystal IS. “We are proud of the team’s accomplishment and its impact on the semiconductor industry as a whole.”
Crystal IS currently produces thousands of 2-inch substrates annually to support the production of its Klaran and Optan product lines. The commercialization of 4-inch AlN substrates will quadruple the device output of the existing footprint of the Green Island facility. It will also enable the development of new applications on aluminum nitride substrates as it integrates into existing fabrication lines for power and RF devices using alternative materials.
Crystal IS will present the progress on 4-inch substrates at this month’s 23rd American Conference on Crystal Growth and Epitaxy in Tucson, Arizona. For more information on Aluminum Nitride and Crystal IS products, visit cisuvc.com or contact [email protected].
About Crystal IS
Crystal IS, an Asahi Kasei company, manufactures UVC LEDs with industry-leading light output and lifetime for disinfection and measurement applications. As the leading pioneer in Aluminum Nitride substrates, Crystal IS UVC LEDs deliver better performance in the ideal germicidal range from 260 – 270 nm to enable sustainable, mercury-free disinfection of water, air and surfaces to ensure healthy life and living around the world. For more information, visit cisuvc.com.
About Asahi Kasei
The Asahi Kasei Group contributes to life and living for people around the world. Since its foundation in 1922 with ammonia and cellulose fiber businesses, Asahi Kasei has consistently grown through the proactive transformation of its business portfolio to meet the evolving needs of every age. With more than 48,000 employees around the world, the company contributes to a sustainable society by providing solutions to the world’s challenges through its three business sectors of Material, Homes, and Health Care. Its Material sector, comprised of Environmental Solutions, Mobility & Industrial, and Life Innovation, includes a wide array of products, from battery separators and biodegradable textiles to engineering plastics and sound solutions. For more information, visit www.asahi-kasei.com.
Contacts
Crystal IS Media Contact:
Liz Facteau
[email protected]
Asahi Kasei America Media Contact:
Christian OKeefe
[email protected]